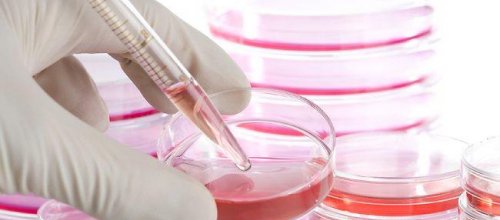
Türkkök Rekora Gidiyor

Son Yazılar
TÜSAP Sağlık Teknolojileri 46. Vizyon Toplantısı
DİJİSAG 2026: Dijital Sağlık Okuryazarlığı Kongresi
Yönetim Kurulu Toplantısı
İVEK Akademi Kurulu Yapılanma ve Altyapı Hazırlık Toplantısı
Ar-Ge ve Biyoteknoloji Komisyon Toplantısı
Genel Müdürlük Toplantısı
Mütevelli Heyeti Başkanımız Sn. Ecz. Öznur Çalık
Yönetim Kurulu Toplantısı
Genç İVEK 4. Öncelikli ve Yenilikçi Araştırmalar Çalıştayı
2 Nisan Dünya Otizm Farkındalık Günü
Türkkök Rekora Gidiyor
2015-04-21 10:17:00
Güney Marmara Bölge Kan Merkezi Kök Hücre Bağışçısı Kazanım Uzmanı Ramazan Çiçek, 40 yılda toplanan kök hücre sayısının 7 ayda toplandığını ifade etti.
